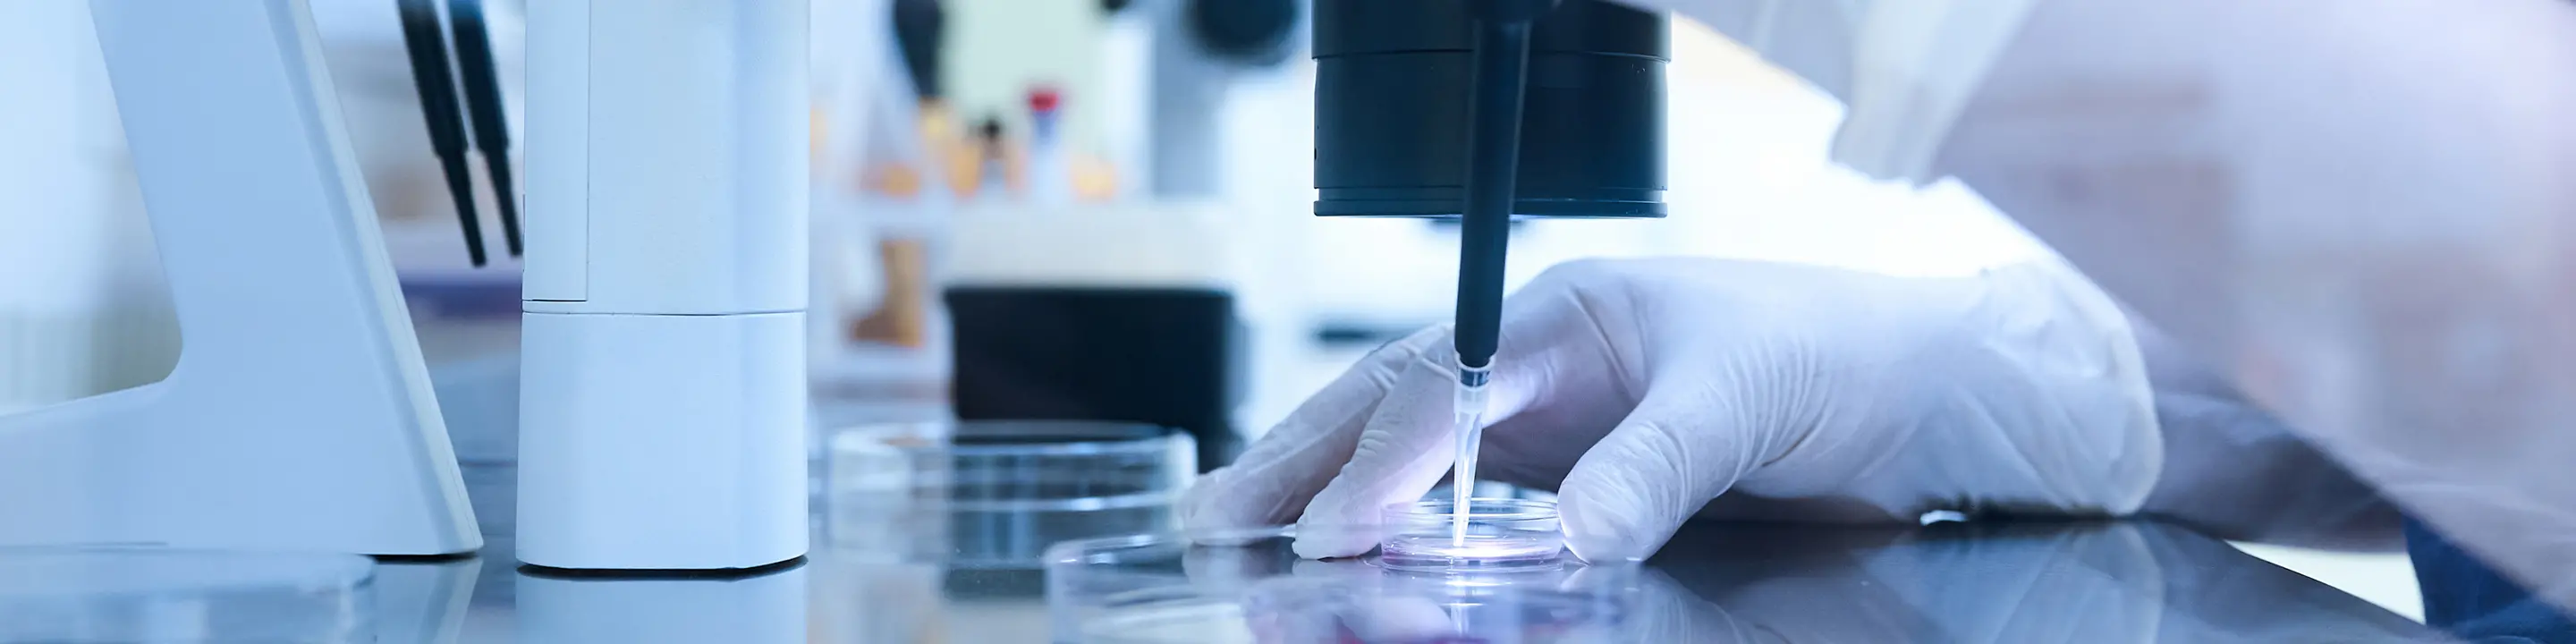
背景画像

Fertility Screening Test
不妊スクリーニング検査
不妊スクリーニング検査について
不妊検査を受けたいけれど必要な項目が分からない…
受けて見たら金額が思ったよりかかってしまった…
そのようなお声を受けてご夫婦で5万円以内に抑えられる不妊スクリーニング検査のパッケージプランを開始いたしました。
ご自身のおからだの状態を把握するうえで必要な検査項目を、女性・男性それぞれパッケージでお受けいただけます。
不妊検査をはじめて受ける方が対象となります。
条件を満たせば東京都にお住まいの場合、上限50,000円まで不妊検査助成金がもらえるため検査費用が実質無料になります。
※東京都の助成金につきましては適用条件や最新情報をこちらよりご確認ください。
※東京都以外でも助成を行っている自治体がございますのでご自身のお住まいの地域のHPなどでご確認ください。
※土曜午後12:30以降は休日加算500円を頂戴いたします。
※パックのため項目の除外は出来かねます。
受けて見たら金額が思ったよりかかってしまった…
そのようなお声を受けてご夫婦で5万円以内に抑えられる不妊スクリーニング検査のパッケージプランを開始いたしました。
ご自身のおからだの状態を把握するうえで必要な検査項目を、女性・男性それぞれパッケージでお受けいただけます。
不妊検査をはじめて受ける方が対象となります。
条件を満たせば東京都にお住まいの場合、上限50,000円まで不妊検査助成金がもらえるため検査費用が実質無料になります。
※東京都の助成金につきましては適用条件や最新情報をこちらよりご確認ください。
※東京都以外でも助成を行っている自治体がございますのでご自身のお住まいの地域のHPなどでご確認ください。
※土曜午後12:30以降は休日加算500円を頂戴いたします。
※パックのため項目の除外は出来かねます。
不妊スクリーニング検査パック
- 女性27,500円(税込)/男性22,000円(税込)
- ご夫婦で受けて49,500円(税込)
料金
SWIPEで全体を確認することが出来ます
プラン
料金(税込)
内容
女性
27,500円(税抜25,000円)
感染症、AMH、風疹抗体、
クラミジア、甲状腺、エコー検査
男性
22,000円(税抜20,000円)
感染症、肝機能、腎機能、血糖値、貧血検査、風疹抗体、ビタミンD、甲状腺、クラミジア、血液型、コレステロール
精液検査(感染症結果出てから検査となります)
※初診料、上記検査が含まれます。
※結果説明は各々1回までとさせていただきます。
※再診料として各々税込1,100円(税抜き1,000円)が別途かかります。
※別途薬剤やサプリが処方された場合は実費で徴収いたします。
※結果説明は各々1回までとさせていただきます。
※再診料として各々税込1,100円(税抜き1,000円)が別途かかります。
※別途薬剤やサプリが処方された場合は実費で徴収いたします。


当日予約もお取りできる
可能性がございます。
03-5159-1101
可能性がございます。
当日枠 月~金 14:00/土曜 12:00/祝日 10:00
お電話受付終了時間 月~金 18:30/土曜 17:30/祝日 13:30
お電話受付終了時間 月~金 18:30/土曜 17:30/祝日 13:30
